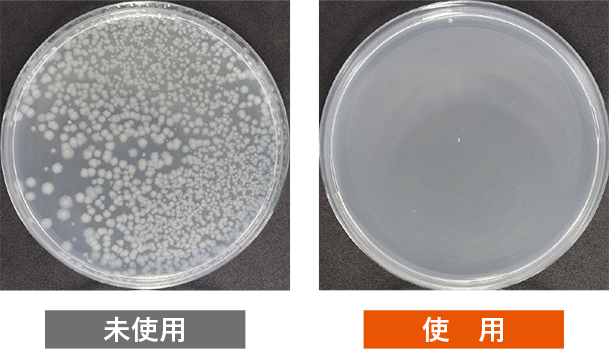
未使用時と使用後の比較

加湿器さぷり






ヌメリの原因菌を除菌、カルキを中和。ピンクヌメリ・カルキ汚れを予防
・小さい給水口でも入れやすい
・給水時に錠剤を入れるだけ
卓上用から大容量タイプまで、様々なサイズの加湿器に対応
アミノ酸+ビタミンC配合自然由来成分100%
抗菌性アミノ酸とは?
微生物による発酵で生産される天然保存料です。試験により高い安全性が確認されており、お弁当やお惣菜、お菓子の保存料など幅広く使用されています。
カルキ対策にビタミンC
水道水などに含まれるカルキを中和。カルキ汚れもつきにくくします。
使い方

【対応機種】給水タンクのある加湿器
空気清浄機能がついた加湿器、ペットボトルに取り付ける加湿器、アロマディフューザーにもお使いいただけます。
加湿器のミストの除菌試験※自社試験
菌を添加し、運転開始から3時間後のミストで比較
除菌試験※自社試験

塩素の除去効果※自社試験

内容量
60錠(約34g)
成分
抗菌性アミノ酸重合体、ビタミンC、有機酸、炭酸ナトリウム、炭酸水素ナトリウム、賦形剤
対応機種
●給水タンクのある加湿器
※空気清浄機能がついた加湿器、ペットボトルに取り付ける加湿器、アロマディフューザーにもお使いいただけます。
使用方法
●タンク給水時に錠剤を入れてください。タンク内の水を除菌することで、雑菌によるヌメリ・悪臭を予防、カルキを軽減します。
※すべての菌・カビに対して効果があるわけではありません。
使用目安
●水量〜3Lに対して、使用量1錠
●水量3〜6Lに対して、使用量2錠
●水量6〜9Lに対して、使用量3錠
使用上の注意
●用途以外には使用しないでください。
●本品は食べられません。
●使用環境により効果は異なります。
●目に入った場合は、こすらずにすぐ水でよく洗い流してください。万一飲み込んだ場合は、水を飲ませる等の処置をして医師に相談してください。
●本品が直接皮膚に付着し、万一異常を感じた場合は医師に相談してください。
●本品を使用し、加湿器等の機器に異常が生じた場合は直ちに使用をおやめください。
●使用時に結晶が現れたり、濁りや沈殿物を生じる場合がございますが、品質に問題はありません。
●錠剤が割れている場合がございますが、そのままご使用いただけます。
●錠剤が黄色やオレンジ色になる場合がありますが、成分の色ですので効果に問題はありません。
●ご使用後はお住まいの自治体が定める方法に従って分別、廃棄してください。
保管上の注意
●小児や認知症の方の手の届くところには置かないでください。
●高温を避け、直射日光の当たらない場所で保管してください。
- この商品のレビュー ☆☆☆☆☆ (0)
- この商品のレビュー ☆☆☆☆☆




